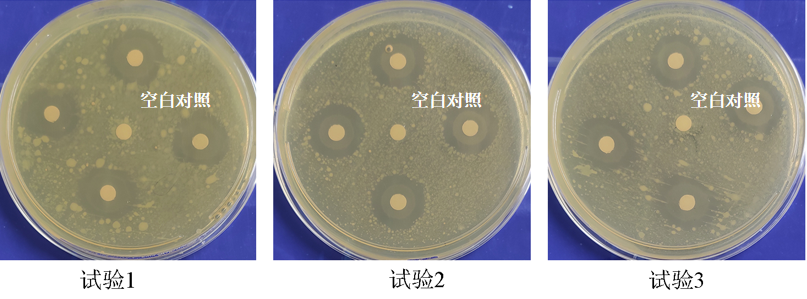
祛痘產(chǎn)品,祛痘功效測定,化妝品,監(jiān)督

引言:
2021年1月1日起施行的《化妝品監(jiān)督管理?xiàng)l例》,明確化妝品注冊人、備案人對(duì)化妝品的質(zhì)量安全和功效宣稱負(fù)責(zé)。《化妝品監(jiān)督管理?xiàng)l例》規(guī)定,化妝品功效宣稱應(yīng)當(dāng)有充分的科學(xué)依據(jù),包括文獻(xiàn)資料、研究數(shù)據(jù)或產(chǎn)品功效評(píng)價(jià)資料等。化妝品注冊人、備案人必須合法真實(shí)標(biāo)注化妝品功效,并在國家藥監(jiān)局規(guī)定的專門網(wǎng)站公布功效宣稱所依據(jù)的文獻(xiàn)資料、研究數(shù)據(jù)或產(chǎn)品功效評(píng)價(jià)資料的摘要,接受社會(huì)監(jiān)督。隨著消費(fèi)者對(duì)產(chǎn)品成分、科學(xué)驗(yàn)證需求的增加,化妝品功效宣稱也越來越關(guān)注其科學(xué)依據(jù)和真實(shí)性,成為行業(yè)關(guān)注的熱點(diǎn)。
痤瘡的形成是一個(gè)復(fù)雜的生理過程,涉及多種因素的相互作用:
- 皮脂腺調(diào)控異常:痤瘡的發(fā)展與皮脂分泌增加、皮脂溢出異常密不可分。皮脂能夠?yàn)槟承┘?xì)菌提供生長條件,導(dǎo)致毛囊內(nèi)環(huán)境變化。
- 毛囊皮脂腺導(dǎo)管角化異常:在痤瘡形成過程中,角質(zhì)形成細(xì)胞展現(xiàn)出過度增殖、異常脫屑、炎癥介質(zhì)的產(chǎn)生等病理變化。正常情況下,毛囊內(nèi)角質(zhì)細(xì)胞會(huì)定期脫落,但在痤瘡患者體內(nèi),這些細(xì)胞可能會(huì)異常粘連導(dǎo)致毛囊口堵塞。這種閉合的環(huán)境有利于細(xì)菌生長和炎癥的發(fā)生。過量皮脂與脫落的角質(zhì)細(xì)胞結(jié)合,形成角栓,堵塞毛囊皮脂腺導(dǎo)管,進(jìn)而產(chǎn)生微粉刺。這些微粉刺可進(jìn)一步發(fā)展為閉合性或開放性粉刺、炎癥性病變,甚至是結(jié)節(jié)或囊腫。

圖1 影響皮膚脂質(zhì)分泌的多種因素(圖源網(wǎng)絡(luò))
3.細(xì)菌感染與炎癥反應(yīng):原稱為痤瘡丙酸桿菌(Propionibacterium acnes)的C.acnes,是正常人及痤瘡患者皮膚上的一種主要共生細(xì)菌。痤瘡的發(fā)生與C.acnes的系統(tǒng)發(fā)育失衡相關(guān),皮膚微生物多樣性的減少及先天免疫反應(yīng)的觸發(fā)可能會(huì)引起痤瘡的慢性炎癥。此細(xì)菌釋放的趨化因子能吸引多形核白細(xì)胞至炎癥區(qū)域。這些細(xì)胞在局部被激活,導(dǎo)致炎癥細(xì)胞因子如TNF-α、IL-1β、IL-6和IL-8的產(chǎn)生。
4.激素水平的變化:雄激素通過刺激脂質(zhì)的合成及皮脂腺細(xì)胞的增殖和分化,在痤瘡形成中起關(guān)鍵作用。雄激素和胰島素樣生長因子1(IGF-1)可以激活PI3K/Akt路徑,進(jìn)而啟動(dòng)哺乳動(dòng)物雷帕霉素靶蛋白(mTOR)的信號(hào)傳遞。雄激素與細(xì)胞核內(nèi)雄激素受體(AR)結(jié)合后,會(huì)增加mTOR的磷酸化水平,并通過組成mTORC1的催化中心,激活固醇調(diào)節(jié)元件結(jié)合蛋白-1(SREBP-1),從而促進(jìn)脂質(zhì)的產(chǎn)生。此外,雄激素還對(duì)內(nèi)源性Wnt/β-catenin信號(hào)通路進(jìn)行負(fù)向調(diào)控,提高Wnt/β-catenin靶基因c-MYC的表達(dá),增強(qiáng)皮脂腺細(xì)胞分化,促使皮脂分泌增加,并通過全分泌方式將內(nèi)容物釋放到皮脂腺導(dǎo)管中。

圖2 痤瘡的皮膚免疫過程
5.遺傳背景:若家庭成員中有人曾患痤瘡,其他家族成員患痤瘡的可能性也會(huì)增加。
6.生活習(xí)慣和飲食因素:攝入高糖食品、高血糖指數(shù)食物以及牛奶和其制品可能會(huì)提高痤瘡的發(fā)生風(fēng)險(xiǎn)。同時(shí),壓力和睡眠質(zhì)量不佳也被視為可能影響?zhàn)畀彴l(fā)展的因素。
痤瘡形成的主要原因是,皮脂分泌過多,屏障功能破壞,皮膚菌群紊亂及炎癥反應(yīng),故分別可從控制皮脂分泌,促進(jìn)角質(zhì)剝落,減少炎癥反應(yīng),抑制痤瘡丙酸桿菌等多方面入手。
1.基于痤瘡丙酸桿菌的祛痘功效測定
痤瘡發(fā)生時(shí),痤瘡丙酸桿菌大量繁殖,從而引起局部組織炎癥。抑制痤瘡丙酸桿菌增殖有助于改善痤瘡。因此,具有抑制痤瘡丙酸桿菌作用的護(hù)膚產(chǎn)品可以在一定程度上幫助預(yù)防痤瘡的產(chǎn)生并控制其進(jìn)一步發(fā)展。常用實(shí)驗(yàn)方法包括:微量肉湯稀釋法測定最小抑菌濃度(MIC);懸液定量法計(jì)算抑菌率;抑菌環(huán)試驗(yàn)(擴(kuò)散法)評(píng)價(jià)抑菌效果。
抑菌環(huán)直徑
圖3 抑菌環(huán)實(shí)驗(yàn)檢測抑菌效果
根據(jù)《WS/T 650—2019》標(biāo)準(zhǔn),通過游標(biāo)卡尺測量抑菌環(huán)直徑對(duì)抗菌效果進(jìn)行分級(jí)。抑菌環(huán)直徑超過7 mm,表明該產(chǎn)品具有抑菌性能;抑菌環(huán)直徑不超過7 mm,表明該產(chǎn)品不具備抑菌效果。通常,抑菌環(huán)直徑越大,抗菌活性越強(qiáng)。抑菌環(huán)大小不止由抗菌物質(zhì)濃度決定,還受到紙片吸收性、待測物擴(kuò)散能力以及培養(yǎng)基的性質(zhì)等因素影響。應(yīng)使用對(duì)照組(例如已知抗生素或無活性溶劑的紙片)以對(duì)比和評(píng)估結(jié)果。
與對(duì)照組相比,樣品組周圍出現(xiàn)明顯的抑菌環(huán)且直徑超7 mm,表明樣品具有祛痘功效。
2.基于炎癥的祛痘功效測定(棕櫚酸鈉、DHT、LPS刺激)
炎癥因子(IL-6、IL-8、TNF-α、IL-1β等)
|
|
|
圖4 樣品作用前后炎癥因子含量及表達(dá)情況
與模型組相比,加入樣品后炎癥因子含量明顯下降,表明樣品具有祛痘功效。
3.基于皮脂腺細(xì)胞/含毛囊皮脂腺的離體皮膚的祛痘功效測定
人皮脂腺細(xì)胞能夠有效模擬人類皮脂腺環(huán)境,因此被廣泛用于研究皮脂腺的生物學(xué)功能和相關(guān)疾病,尤其是痤瘡。脂滴是細(xì)胞內(nèi)儲(chǔ)存中性脂肪的地方,與甘油三酯的生成及代謝緊密相關(guān)。脂滴數(shù)量和大小的變化標(biāo)志著皮脂腺細(xì)胞的分化過程。因此,在使用SZ95細(xì)胞評(píng)估原料或產(chǎn)品的抗痘功效時(shí),我們可以觀察細(xì)胞的形態(tài)變化,測定脂滴大小和數(shù)量,并檢測核受體及PPAR、SREBP-1和FAS等相關(guān)基因和蛋白的表達(dá)情況。

圖5 脂質(zhì)代謝相關(guān)通路
脂滴含量(Nile red)
 |  |
圖6 樣品作用前后脂滴分布情況
與模型組相比,樣品組隨著濃度升高,紅色熒光強(qiáng)度逐漸減弱,表明樣品能有效抑制皮脂腺細(xì)胞皮脂分泌,有一定的祛痘功效。
基于包含毛囊和皮脂腺的離體人皮膚組織模型進(jìn)行的檢測:通過模擬人體使用過程,調(diào)整樣品濃度和配方,以表面給藥形式將樣品均勻涂抹在離體人皮膚模型表面。將處理過的皮膚模型放在適宜的培養(yǎng)條件下,通常包括恒溫和適當(dāng)?shù)臐穸瓤刂啤Mㄟ^觀察模型組織的形態(tài)、脂滴的生成以及皮脂腺相關(guān)蛋白和基因表達(dá)變化,評(píng)估待測化妝品在控油和祛痘方面的效果。
護(hù)膚原料和產(chǎn)品的功效評(píng)估對(duì)于研發(fā)、市場營銷及行業(yè)監(jiān)管至關(guān)重要,在確保消費(fèi)者滿意度和信任度、增強(qiáng)市場競爭力等方面發(fā)揮著不可替代的作用。而體外功效評(píng)價(jià)技術(shù)的進(jìn)步與創(chuàng)新對(duì)于推動(dòng)整個(gè)行業(yè)的發(fā)展具有決定性作用。我們的祛痘體外功效評(píng)估今天就先講到這里,如果您有疑問或建議歡迎評(píng)論區(qū)留言。
參考文獻(xiàn):
- 何陵玲,張毅,龔秋君,等.痤瘡的機(jī)理癥狀及祛痘型護(hù)膚品功效類型[J].日用化學(xué)工業(yè),2020,50(05):336-342.
- 袁超.從化妝品新規(guī)看祛痘功效的評(píng)價(jià)[J].皮膚科學(xué)通報(bào),2022,39(01):66-69+8.
- 張婷婷,吳黎明,吳田田,等.祛痘功效成分的技術(shù)研究與產(chǎn)品應(yīng)用的開發(fā)展望[J].中國化妝品,2024,(01):98-103.
- Hana L ,Donghyun H ,Minjoo L , et al.Micro-Current Stimulation Suppresses Inflammatory Responses in Peptidoglycan-Treated Raw 264.7 Macrophages and Propionibacterium acnes-Induced Skin Inflammation via TLR2/NF-κB Signaling Pathway[J].International Journal of Molecular Sciences,2022,23(5):2508-2508.
- Jin Z ,Song Y ,He L .A review of skin immune processes in acne.[J].Frontiers in immunology,2023,141324930-1324930.




